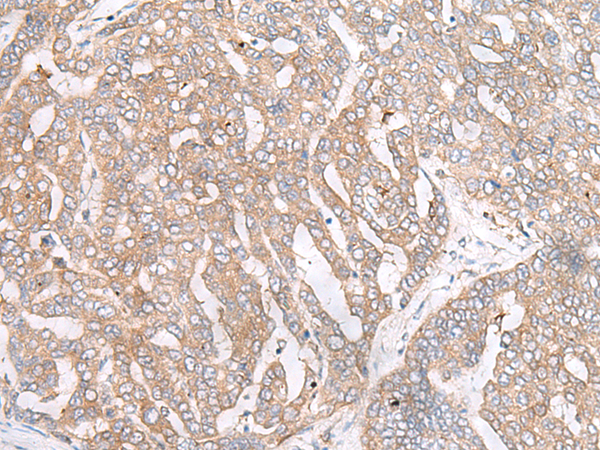

中文名稱: 兔抗RPL23A多克隆抗體
英文名稱: Anti-RPL23A rabbit polyclonal antibody
別 名: ribosomal protein L23a; L23A; MDA20
相關(guān)類別: 一抗
儲(chǔ) 存: 冷凍(-20℃)
宿 主: Rabbit
抗 原: RPL23A
反應(yīng)種屬: Human, Mouse, Rat
標(biāo) 記 物: Unconjugate
克隆類型: rabbit polyclonal
技術(shù)規(guī)格
|
Background: |
Ribosomes, the organelles that catalyze protein synthesis, consist of a small 40S subunit and a large 60S subunit. Together these subunits are composed of 4 RNA species and approximately 80 structurally distinct proteins. This gene encodes a ribosomal protein that is a component of the 60S subunit. The protein belongs to the L23P family of ribosomal proteins. It is located in the cytoplasm. The protein may be one of the target molecules involved in mediating growth inhibition by interferon. In yeast, the corresponding protein binds to a specific site on the 26S rRNA. This gene is co-transcribed with the U42A, U42B, U101A, and U101B small nucleolar RNA genes, which are located in its third, first, second, and fourth introns, respectively. As is typical for genes encoding ribosomal proteins, there are multiple processed pseudogenes of this gene dispersed through the genome. |
|
Applications: |
ELISA, WB, IHC |
|
Name of antibody: |
RPL23A |
|
Immunogen: |
Fusion protein of human RPL23A |
|
Full name: |
ribosomal protein L23a |
|
Synonyms: |
L23A; MDA20 |
|
SwissProt: |
P62750 |
|
ELISA Recommended dilution: |
5000-10000 |
|
IHC positive control: |
Human liver cancer |
|
IHC Recommend dilution: |
50-300 |
|
WB Predicted band size: |
18 kDa |
|
WB Positive control: |
293T cell lysate |
|
WB Recommended dilution: |
200-1000 |

購(gòu)物車
購(gòu)物車 幫助
幫助
 021-54845833/15800441009
021-54845833/15800441009
